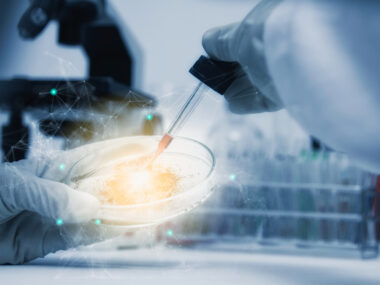
early statin study

Lovastatin, Minocycline Combined Helps Fragile X Behavior, Caregivers Report
Written by |

A combination of approved medicines — lovastatin and minocycline — significantly improved several behavioral characteristics in adults with fragile X syndrome, according to caregivers who participated in a Phase 2 clinical trial.
The researchers said they believed this was the first trial to assess the safety and effectiveness of “a combined disease-modifying add on treatment in [fragile X] individuals.”
The study, “Combining Lovastatin and Minocycline for the Treatment of Fragile X Syndrome: Results From the LovaMiX Clinical Trial,” was published in Frontiers in Psychiatry.
Fragile X is caused by a genetically-inherited deficiency of the FMRP protein, which controls the production of other proteins involved in nerve cell communication.
A lack of FMRP leads to moderate to severe intellectual disability in males, often with aggression and social avoidance, while females generally show milder and broader cognitive traits. Current therapies, including antidepressants, stimulants, and antipsychotics primarily treat symptoms with limited effectiveness.
Because of the multiple downstream pathways affected by FMRP deficiency, researchers have considered combining medications to modulate the pathways and correct patients’ cognition and behaviors.
Lovastatin is an approved therapy designed to decrease cholesterol and other fat-like substances in the bloodstream and reduce the risk of heart disease and stroke. Minocycline is an antibiotic used to treat bacterial infections. On their own, they have shown promise in correcting behaviors in fragile X children, adolescents, and adults.
“Lovastatin and minocycline target specific pathways affected by the absence of FMRP and have shown promising effect in previous clinical trials,” investigators at the Université de Sherbrooke in Québec, Canada said.
The team conducted a Phase 2, open-label clinical trial (NCT02680379) to evaluate how safe and effective it might be to combine lovastatin and minocycline in adults with fragile X.
“We hypothesized that the combination of lovastatin and minocycline, each targeting distinct pathways, may have synergistic effects on cognition and behavior in individuals with [fragile X] while not having added adverse effects,” researchers wrote.
The study enrolled 22 adults (19 males, three females), ages 20 to 26, with severe intellectual disabilities, and a caregiver (at least six hours per day) who attended all the visits.
Eleven participants were randomly assigned to receive 20 mg of lovastatin for four weeks, then 40 mg for four more weeks, followed by 12 weeks (three months) of 40 mg lovastatin plus 100 mg of minocycline.
The remaining group was treated with 50 mg of minocycline for four weeks, 100 mg for four weeks, then 100 mg minocycline plus 40 mg lovastatin for 12 weeks.
The study’s primary goal was to see behavioral improvements as indicated by the global score of the aberrant behavior checklist-community (ABC-C) — a caregiver rating scale to assess behavioral problems’ severity.
After 20 weeks of treatment in total, there was a 40% improvement in the global ABC-C score, regardless of the first prescribed medication.
Improvements were also seen in total scores and subscales of secondary outcomes, as measured by the anxiety, depression, and mood scale (ADAMS), the behavior rating inventory of executive functions (BRIEF), and the social responsiveness scale (SRS).
Combination treatment significantly improved ABC-C subscores for lethargy, hyperactivity, inappropriate speech, and social avoidance. ADAMS subscores for hyperactivity, social avoidance, and general anxiety were also significantly better, as were those of BRIEF, such as impulse control, tolerance for change, emotional control, and working memory.
Almost all the subscores from the SRS assessment showed significantly enhanced cognition, communication, motivation, and mannerisms behavior.
The research team did examine and compare the effectiveness of each treatment alone because patients were first treated with either lovastatin or minocycline for eight weeks.
Although improvements were seen in most subscales, they were rarely statistically significant, possibly due to the “combination of small sample size (11) and a short duration of treatment (8 weeks),” the scientists wrote.
Eight weeks of lovastatin significantly improved hyperactivity and social avoidance in ABC-C sub-scales, both significantly after combined treatment. In contrast, eight weeks of minocycline significantly reduced lethargy, but was better when the medicines were used together. Inappropriate speech declined with combined therapy, but not with lovastatin or minocycline alone.
The BRIEF sub-scores for impulse control and change tolerance were better with either lovastatin or minocycline. Emotional control scores improved with lovastatin alone.
Lovastatin, but not minocycline, significantly improved the total SRS score and almost all sub-scores after eight weeks of treatment. “ …beside SRS who appeared more specific to lovastatin treatment, we were unable to determine if lovastatin and minocycline improve differently, specific traits highlighted in those questionnaires,” the scientists noted.
Reported side effects were mild or moderate, except for one participant who had a severe increase in the enzyme alanine transaminase (ALT) in the bloodstream, a marker for liver damage, during combined treatment.
Compared to the first eight-week mono-therapy phase, more side effects occurred with the combined treatment. As seen in other studies, the researchers noted that a few patients reported headaches during lovastatin treatment. Elevated creatine kinase in the blood, a marker for muscle damage, occurred in most, but patients reported no muscle pains.
Because a previous fragile X study showed minocycline treatment was associated with generating antinuclear antibodies (ANA) — a sign the immune system is targeting healthy tissues (autoimmunity) — additional blood tests were conducted. Although a few participants were ANA-positive before treatment, no ANA increases were seen during this trial.
“This study, clearly showing the security of a combined treatment would certainly alleviate caregiver apprehension on adverse effects and facilitate recruitment for future trials using a combined treatment of lovastatin/minocycline,” the researchers wrote.
“Our study also paves the way for future trials using other combined treatment that would better compensate for the absence of FMRP and improve the natural evolution of [fragile X] individuals and alleviate families’ burden,” they added.

Leave a comment
Fill in the required fields to post. Your email address will not be published.